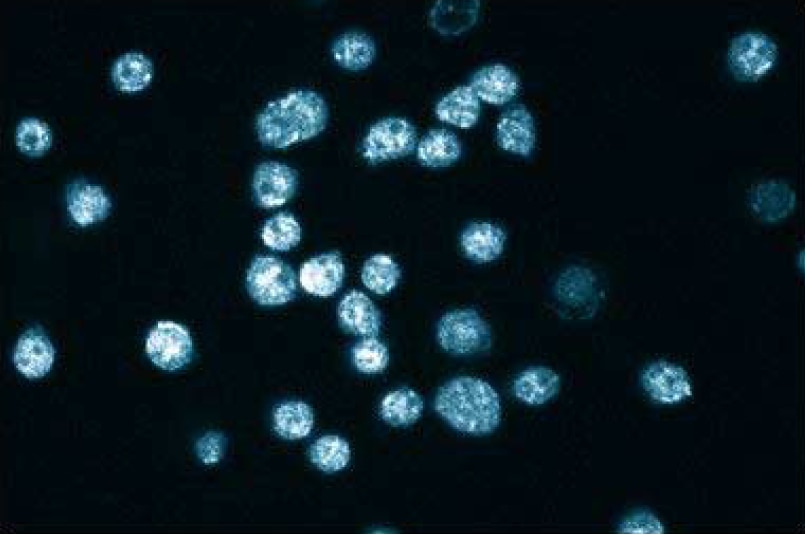
P63420_610788_image2.png

-
Reagents
- Flow Cytometry Reagents
-
Western Blotting and Molecular Reagents
- Immunoassay Reagents
-
Single-Cell Multiomics Reagents
- BD® OMICS-Guard Sample Preservation Buffer
- BD® AbSeq Assay
- BD® Single-Cell Multiplexing Kit
- BD Rhapsody™ ATAC-Seq Assays
- BD Rhapsody™ Whole Transcriptome Analysis (WTA) Amplification Kit
- BD Rhapsody™ TCR/BCR Next Multiomic Assays
- BD Rhapsody™ Targeted mRNA Kits
- BD Rhapsody™ Accessory Kits
- BD® OMICS-One Protein Panels
-
Functional Assays
-
Microscopy and Imaging Reagents
-
Cell Preparation and Separation Reagents
-
- BD® OMICS-Guard Sample Preservation Buffer
- BD® AbSeq Assay
- BD® Single-Cell Multiplexing Kit
- BD Rhapsody™ ATAC-Seq Assays
- BD Rhapsody™ Whole Transcriptome Analysis (WTA) Amplification Kit
- BD Rhapsody™ TCR/BCR Next Multiomic Assays
- BD Rhapsody™ Targeted mRNA Kits
- BD Rhapsody™ Accessory Kits
- BD® OMICS-One Protein Panels
- Poland (English)
-
Change location/language
Old Browser
This page has been recently translated and is available in French now.
Looks like you're visiting us from {countryName}.
Would you like to stay on the current location site or be switched to your location?
BD Transduction Laboratories™ Purified Mouse Anti-Human Plakophilin 2
Clone 28/Plakophilin (RUO)





Western blot analysis of Plakophilin 2 on a HepG2 cell lysate (Human hepatocellular carcinoma; ATCC HB-8065). Lane 1: 1:250, lane 2: 1:500, lane 3: 1:1000 dilution of the mouse anti-human Plakophilin 2 antibody.

Western blot analysis of Plakophilin 2 on a HepG2 cell lysate (Human hepatocellular carcinoma; ATCC HB-8065). Lane 1: 1:250, lane 2: 1:500, lane 3: 1:1000 dilution of the mouse anti-human Plakophilin 2 antibody.

Immunofluorescence staining of HL-60 cells (Human promyelocytic leukemia; ATCC CCL-240).

Regulatory Status Legend
Any use of products other than the permitted use without the express written authorization of Becton, Dickinson and Company is strictly prohibited.
Preparation And Storage
Recommended Assay Procedures
Western blot: Please refer to http://www.bdbiosciences.com/pharmingen/protocols/Western_Blotting.shtml
Product Notices
- Since applications vary, each investigator should titrate the reagent to obtain optimal results.
- Please refer to www.bdbiosciences.com/us/s/resources for technical protocols.
- Caution: Sodium azide yields highly toxic hydrazoic acid under acidic conditions. Dilute azide compounds in running water before discarding to avoid accumulation of potentially explosive deposits in plumbing.
- Source of all serum proteins is from USDA inspected abattoirs located in the United States.
Companion Products


Plakophilin 2 is a desmosomal plaque protein that belongs to the "arm" repeat family of proteins. Alternative splicing results in two isoforms: 2a (837 aa) and 2b (881 aa). The 2b isoform contains an insertion of 44 aa in the arm repeat unit 2. Other arm family members are ß-catenin, plakophilin 1, plakoglobin, pp120, and armadillo of Drosophila gene product. They have at least 9 repeats of the arm motif, which consists of approximately 42 aa, and a short carboxyl terminus. Plakophilins are constitutively expressed in desmosome-containing cells. Plakophilin 1 has been found only in desmosomal-containing cells, such as stratified and complex epithelia. Plakophilin 2 has been isolated from both desmosomal as well as non-desmosomal forming cells, including simple and glandular epithelia, and from nonepithelial tissues such as the mycocardium and Purkinje fibers. In addition, Plakophilin 2 is found in the karyoplasm of interphase cells. Plakophilins 2a and 2b are part of desmosomal plaques, although they are located primarily in the karyoplasm of the interphase nucleus. The function of nuclear plakophilin 2 remains to be identified.
Development References (1)
-
Mertens C, Kuhn C, Franke WW. Plakophilins 2a and 2b: constitutive proteins of dual location in the karyoplasm and the desmosomal plaque. J Cell Biol. 1996; 135(4):1009-1025. (Biology). View Reference
Please refer to Support Documents for Quality Certificates
Global - Refer to manufacturer's instructions for use and related User Manuals and Technical data sheets before using this products as described
Comparisons, where applicable, are made against older BD Technology, manual methods or are general performance claims. Comparisons are not made against non-BD technologies, unless otherwise noted.
Please refer to Support Documents for Quality Certificates
Global - Refer to manufacturer's instructions for use and related User Manuals and Technical data sheets before using this products as described
Comparisons, where applicable, are made against older BD Technology, manual methods or are general performance claims. Comparisons are not made against non-BD technologies, unless otherwise noted.
For Research Use Only. Not for use in diagnostic or therapeutic procedures.